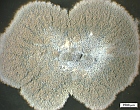

Latest Empa Spin-off founded: «Dr. Paul Raschle – Microbiological Expertise»
Microbiological building damage analysis in new hands after Empa spin-off
When the provision of a scientific or technical service becomes profitable, then researchers metamorphose into entrepreneurs and often establish a spin-off company. This is the path followed by Paul Raschle, for many years Empa’s resident microbiological expert and consultant in the field of civil engineering and cultural assets. Since the beginning of this month his newly founded company «Dr. Paul Raschle – Microbiological Expertise» has been offering expert advice to, for example, civil engineering professionals in dealing with unwanted organic infestation or damage due to fungal infection and other microorganisms.

|
Fungus grows readily in many different places. A few common examples are in cracks in a bathtub, in the joints of a tiled shower surface and on building façades. Water vapor in the air condenses readily on cold walls, and this condensation is, so to say, the elixir of life for algae and fungus on external walls and also for mildew on inside walls. |
|||
| The consequences can be costly renovation work and sometimes even health problems, particularly for people with allergies. The greatest difficulty in dealing with this problem is that it is often too late by the time that the first traces of infestation are discovered. For many years now Paul Raschle, Empa’s in-house expert, has been investigating and doing battle with mildew and dry rot, the two commonest forms of fungal infestation in buildings. Mildew represents primarily a health risk, since it can trigger allergic reactions, and dry rot is a dreaded destroyer of wood. | ||||
|
In earlier times it used to be said that the only solution to dry rot infestation was to demolish the structure. Fortunately this is no longer true, and Raschle’s microbiological expertise frequently serves as the basis for a renovation program. His professional advice has already helped to save not just countless “normal” buildings, but also many artistically and historically valuable cultural artifacts and listed buildings. It has also been valuable in keeping renovation and restoration costs to a minimum in such cases. |
|||
|
Sometimes, however, there are no simple solutions and expensive, time-consuming conservation work is the only option available. Examples of this are when fungus attacks a painting after it has suffered water damage, when mildew develops on the ceiling frescos of a church, or when microorganisms threaten to destroy the plasterwork of a historic building. Consultancy services in the field of civil engineering microbiology and cultural asset conservancy is thus the business idea behind the newest Empa spin-off, Pauls Raschle’s new firm which began operating at the beginning of October under the name «Dr. Paul Raschle – Microbiological Expertise». |
||||
|
Many years of Empa know-how forms the basis of the start-up If something is growing where it shouldn’t be, then Paul Raschle is the man to talk to. Building engineers and owners, insurance investigators, tenants or property managers – since 1977 they have all been given good advice by the microbiologist who, among his other responsibilities, also acts as biological expert to the Swiss Federal Office for Culture in the field of conservation of cultural assets. He has got to know practically every Swiss cloister, including that in Einsiedeln, his “first big job”. |
|||
|
For Paul Raschle, his work represents “permanent research”, since every new case is really a “prototype” which presents him with a fresh challenge and which in the end extends his know-how and experience. And as Raschle himself says, this kind of work is only possible “when one has years of experience to fall back on”. As a biologist, he often works together with professionals from other disciplines, being frequently accompanied by a specialist in building-physics, for example, or an architect, whose responsibility is to evaluate the condition of the insulation material or structure of a building. After a thorough investigation, Rasche prepares a diagnosis of the problem and lists the most appropriate measures to be taken to counter the microbiological infestation and protect the building or work of art from future attack. He also makes clear the consequences of doing nothing. But Raschle’s work is not complete yet; when necessary he also offers support and advice while the remedial measures he has suggested are being implemented. Only when the damage has been completely repaired and the cause eradicated does Paul Raschle tick off the job as completed. Author: Manuel Martin Editorial: Further technical Information: |
||||
|
|||